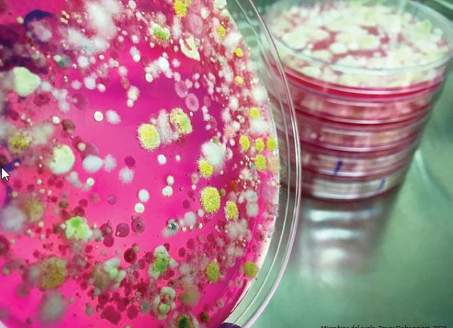

Durante siglos, el arte ha servido de espejo a la sociedad, que refleja fielmente las dinámicas culturales, políticas y sociales de las distintas épocas.
Si se mira más allá de la superficie de una creación artística, es posible descubrir un mundo de significado escondido en el contenido de una simple copa o jarra. Las bebidas han servido como inspiración creativa del arte, la música y el diseño.
Las antiguas tumbas egipcias contienen pinturas de escenas de elaboración de cerveza y consumo de vino. En el arte clásico griego y romano, el dios del vino -Dionisio o Baco- era un tema popular que simbolizaba no solo la embriaguez y el jolgorio, sino también las fuerzas primarias de la naturaleza y el misterio de la vida y la muerte.
Pero lo cierto es que esta sensibilidad para convertir lo cotidiano en arte ha trascendido hasta la época contemporánea. Así tenemos a Andy Warhol (1928-1987), quien en 1962 creó una icónica obra con la técnica de serigrafía que representa tres botellas de la famosa marca de refrescos, en tonos llamativos y vibrante1-3.
Aún más atrás en el tiempo, la lectura nos lleva al descubrimiento de muchos tipos diferentes de expresión artística, que no se limitan únicamente a las llamadas “bellas artes”. Así, nos topamos con expresiones artísticas insospechadas, como el caso de Alexander Fleming, conocido por el descubrimiento de la penicilina. Pero, además, le gustaba pintar. En su relación con las bacterias descubrió que producían diversos colores, y con ellas realizó algunos cuadros que se conservan en el museo que lleva su nombre4.
Así como los ingredientes alcohólicos -vodka, ron, ginebra o whisky- y los no alcohólicos -jarabes, frutas y hierbas frescas-, junto con el talento de un bartender, juegan un papel crucial en la base de cualquier buen coctel, unas pocas herramientas y materias primas en las manos habilidosas de una persona con sensibilidad especial para la belleza pueden abrir nuevos caminos para la creación artística y desafiar las normas del arte convencional. Tal es el caso de Lester Hutt, quien, armado con una pipeta y un microscopio de alta resolución, realizó algo muy original. Pipeta en mano, tomó una gota de diversas bebidas alcohólicas, tales como: vodka, piña colada, sake, martini, martini seco, champagne, vino tinto, refresco de cola, whiskey y chablis5.
La técnica consistía en colocar una gota de cada una de estas sustancias espirituosas sobre diferentes portaobjetos, que dejaba secar dentro de un recipiente hermético durante aproximadamente cuatro semanas, para que se evaporara el alcohol, aunque el procedimiento completo podía tardar hasta tres meses. El siguiente paso era observarlas con un microscopio de altos aumentos fabricado por la empresa Bevshots, y fotografiar los campos que observaba. Las coloridas imágenes que obtuvo correspondían a los carbohidratos cristalizados. Cada imagen es una obra que identifica a cada bebida y, al mirarlas, no queda más que reconocer el toque artístico de la naturaleza, que no siempre es accesible al poder de resolución del ojo humano6.
Ellin Thomas utiliza las placas de Petri como marco para sus obras de arte, con ayuda de bacterias y hongos. Coloca una base de lana afieltrada, agrega algunos bordados y deja que las bacterias y los hongos trabajen7.
Tracy Devenport, microbióloga con un interés especial en los hongos, aprovecha su conocimiento de estos organismos y les permite crear obras de arte que ella misma fotografía. Esta actividad le ha permitido ganar varios premios. Sus imágenes están llenas de colorido, formas y composiciones diversas, y al observarlas, no siempre se pensaría que esa microfotografía corresponde a un hongo capaz de producir un antibiótico que ha salvado muchas vidas8.
Resulta igual de asombroso visualizar la belleza de los cristales de una de las bebidas azucaradas de mayor consumo y, al mismo tiempo, leer sobre todos los problemas de salud que estas ocasionan9.
Estos creadores rompen las barreras entre el arte y la vida cotidiana, y nos demuestran lo importante que es, para el profesional de la salud, tener un acervo cultural que vaya más allá de la ciencia médica para ser un médico excepcional. El gran médico, además del conocimiento científico, integra a sus competencias habilidades, visión, adaptabilidad, ética y humanidades, pues “el médico que solo sabe de medicina, ni de medicina sabe”10,11.